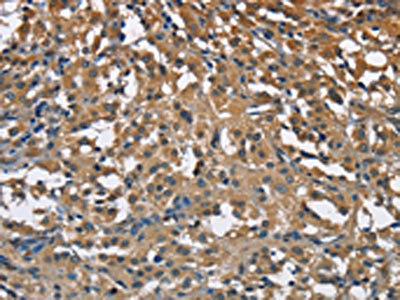
CSB-PA205920

ENO1
ENO1,即烯醇化酶1,別名NNE、PPH、MPB-1,由人類ENO1基因編碼,該基因位于1號染色體的p36.2位置。
ENO1蛋白是一種糖酵解過程中的關鍵酶,同時也是眼睛晶狀體的重要組分。它不僅參與糖代謝,還參與調控纖溶酶原激活和纖溶酶活性過程,促進肌生成和肌肉再生,調控細胞凋亡以及腫瘤發生發展過程。
ENO1在細胞內外表達量的變化與多種疾病的發生發展過程密切相關,如阿爾茲海默病、類風濕關節炎、腫瘤、心血管疾病等,具有潛在的疾病診斷和預后價值。
熱銷產品
Recombinant Human Alpha-enolase (ENO1) (CSB-YP007670HU)
驗證數據

(Tris-Glycine gel) Discontinuous SDS-PAGE (reduced) with 5% enrichment gel and 15% separation gel.
驗證數據

The image on the left is immunohistochemistry of paraffin-embedded Human liver cancer tissue using CSB-PA205920(ENO1 Antibody) at dilution 1/40, on the right is treated with fusion protein. (Original magnification: ×200)
The image on the left is immunohistochemistry of paraffin-embedded Human thyroid cancer tissue using CSB-PA205920(ENO1 Antibody) at dilution 1/40, on the right is treated with fusion protein. (Original magnification: ×200)

Gel: 8%SDS-PAGE, Lysate: 40 μg, Lane 1-5: Hela cells, A431 cells, mouse brain tissue, Mouse liver tissue, mouse pancreas tissue, Primary antibody: CSB-PA205920(ENO1 Antibody) at dilution 1/500, Secondary antibody: Goat anti rabbit IgG at 1/8000 dilution, Exposure time: 10 seconds
ENO1 Antibodies
ENO1 for Homo sapiens (Human)
| 產品貨號 | 產品名稱 | 種屬反應性 | 應用類型 |
|---|---|---|---|
| CSB-PA007670GA01HU | ENO1 Antibody | Human,Mouse,Rat | ELISA,WB |
| CSB-PA02395A0Rb | ENO1 Antibody | Human, Mouse | ELISA, WB, IHC, IF |
| CSB-PA02395D0Rb | ENO1 Antibody, Biotin conjugated | Human | ELISA |
| CSB-PA821534 | ENO1 Antibody | Human,Mouse,Rat | ELISA,WB,IHC |
| CSB-PA205920 | ENO1 Antibody | Human,Mouse,Rat | ELISA,WB,IHC |
| CSB-MA007670A0m | ENO1 Monoclonal Antibody | Human, Mouse, Rat, Rabbit | ELISA, WB, IHC, IF, FC, IP |
| CSB-MA007670A1m | ENO1 Monoclonal Antibody | Human, Rabbit | ELISA, WB, IF, FC, IP |
ENO1 for Mus musculus (Mouse)
| 產品貨號 | 產品名稱 | 種屬反應性 | 應用類型 |
|---|---|---|---|
| CSB-PA007670HD01MO | Eno1 Antibody, Biotin conjugated | Mouse | ELISA |
| CSB-PA007670HB01MO | Eno1 Antibody, HRP conjugated | Mouse, Rat, Human | ELISA, WB |
| CSB-PA007670HA01MO | Eno1 Antibody | Mouse, Human | ELISA, WB |
ENO1 Proteins
ENO1 Proteins for Mus musculus (Mouse)
| 產品貨號 | 產品名稱 | 來源 |
|---|---|---|
| CSB-BP007670MO CSB-MP007670MO CSB-EP007670MO-B |
Recombinant Mouse Alpha-enolase (Eno1), partial | Baculovirus Mammalian cell In Vivo Biotinylation in E.coli |
| CSB-EP007670MO | Recombinant Mouse Alpha-enolase (Eno1), partial | E.coli |
| CSB-EP007670MOb0 | Recombinant Mouse Alpha-enolase (Eno1), partial | E.coli |
ENO1 Proteins for Gallus gallus (Chicken)
| 產品貨號 | 產品名稱 | 來源 |
|---|---|---|
| CSB-YP007670CH CSB-EP007670CH CSB-BP007670CH CSB-MP007670CH CSB-EP007670CH-B |
Recombinant Chicken Alpha-enolase (ENO1) | Yeast E.coli Baculovirus Mammalian cell In Vivo Biotinylation in E.coli |
ENO1 Proteins for Rattus norvegicus (Rat)
| 產品貨號 | 產品名稱 | 來源 |
|---|---|---|
| CSB-YP007670RA CSB-EP007670RA CSB-BP007670RA CSB-MP007670RA CSB-EP007670RA-B |
Recombinant Rat Alpha-enolase (Eno1) | Yeast E.coli Baculovirus Mammalian cell In Vivo Biotinylation in E.coli |
ENO1 Proteins for Homo sapiens (Human)
| 產品貨號 | 產品名稱 | 來源 |
|---|---|---|
| CSB-EP007670HU CSB-MP007670HU CSB-EP007670HU-B |
Recombinant Human Alpha-enolase (ENO1) | E.coli Mammalian cell In Vivo Biotinylation in E.coli |
| CSB-EP007670HU1 | Recombinant Human Alpha-enolase (ENO1), partial | E.coli |
| CSB-BP007670HU | Recombinant Human Alpha-enolase (ENO1) | Baculovirus |
| CSB-BP007670HUd8 | Recombinant Human Alpha-enolase (ENO1) | Baculovirus |
| CSB-YP007670HU | Recombinant Human Alpha-enolase (ENO1) | Yeast |
| CSB-YP007670HUf3 | Recombinant Human Alpha-enolase (ENO1) | Yeast |
ENO1 Proteins for Mesocricetus auratus (Golden hamster)
| 產品貨號 | 產品名稱 | 來源 |
|---|---|---|
| CSB-YP007670MRG CSB-EP007670MRG CSB-BP007670MRG CSB-MP007670MRG CSB-EP007670MRG-B |
Recombinant Mesocricetus auratus Alpha-enolase (ENO1) | Yeast E.coli Baculovirus Mammalian cell In Vivo Biotinylation in E.coli |
ENO1 Proteins for Anas platyrhynchos (Domestic duck) (Anas boschas)
| 產品貨號 | 產品名稱 | 來源 |
|---|---|---|
| CSB-YP007670BZD CSB-EP007670BZD CSB-BP007670BZD CSB-MP007670BZD CSB-EP007670BZD-B |
Recombinant Anas platyrhynchos Alpha-enolase (ENO1) | Yeast E.coli Baculovirus Mammalian cell In Vivo Biotinylation in E.coli |
ENO1 Proteins for Xenopus laevis (African clawed frog)
| 產品貨號 | 產品名稱 | 來源 |
|---|---|---|
| CSB-YP007670XBE CSB-EP007670XBE CSB-BP007670XBE CSB-MP007670XBE CSB-EP007670XBE-B |
Recombinant Xenopus laevis Alpha-enolase (eno1) | Yeast E.coli Baculovirus Mammalian cell In Vivo Biotinylation in E.coli |
ENO1 Proteins for Lactococcus lactis subsp. cremoris (strain SK11)
| 產品貨號 | 產品名稱 | 來源 |
|---|---|---|
| CSB-YP312687LBE CSB-EP312687LBE CSB-BP312687LBE CSB-MP312687LBE CSB-EP312687LBE-B |
Recombinant Lactococcus lactis subsp. cremoris Enolase 1 (eno1) | Yeast E.coli Baculovirus Mammalian cell In Vivo Biotinylation in E.coli |
ENO1 Proteins for Candida albicans (strain SC5314 / ATCC MYA-2876) (Yeast)
| 產品貨號 | 產品名稱 | 來源 |
|---|---|---|
| CSB-YP326983CZD CSB-EP326983CZD CSB-BP326983CZD CSB-MP326983CZD CSB-EP326983CZD-B |
Recombinant Candida albicans Enolase 1 (ENO1) | Yeast E.coli Baculovirus Mammalian cell In Vivo Biotinylation in E.coli |
ENO1 Proteins for Zea mays (Maize)
| 產品貨號 | 產品名稱 | 來源 |
|---|---|---|
| CSB-YP335188ZAX CSB-EP335188ZAX CSB-BP335188ZAX CSB-MP335188ZAX CSB-EP335188ZAX-B |
Recombinant Zea mays Enolase 1 (ENO1) | Yeast E.coli Baculovirus Mammalian cell In Vivo Biotinylation in E.coli |
ENO1 Proteins for Saccharomyces cerevisiae (strain ATCC 204508 / S288c) (Baker's yeast)
| 產品貨號 | 產品名稱 | 來源 |
|---|---|---|
| CSB-YP365489SVG CSB-EP365489SVG CSB-BP365489SVG CSB-MP365489SVG CSB-EP365489SVG-B |
Recombinant Saccharomyces cerevisiae Enolase 1 (ENO1) | Yeast E.coli Baculovirus Mammalian cell In Vivo Biotinylation in E.coli |
ENO1 Proteins for Desulfitobacterium hafniense (strain Y51)
| 產品貨號 | 產品名稱 | 來源 |
|---|---|---|
| CSB-YP636598DAAE CSB-EP636598DAAE CSB-BP636598DAAE CSB-MP636598DAAE CSB-EP636598DAAE-B |
Recombinant Desulfitobacterium hafniense Enolase 1 (eno1) | Yeast E.coli Baculovirus Mammalian cell In Vivo Biotinylation in E.coli |
ENO1 Proteins for Ralstonia metallidurans (strain CH34 / ATCC 43123 / DSM 2839)
| 產品貨號 | 產品名稱 | 來源 |
|---|---|---|
| CSB-YP636833RJG CSB-EP636833RJG CSB-BP636833RJG CSB-MP636833RJG CSB-EP636833RJG-B |
Recombinant Ralstonia metallidurans Enolase 1 (eno1) | Yeast E.coli Baculovirus Mammalian cell In Vivo Biotinylation in E.coli |
ENO1 Proteins for Methanospirillum hungatei (strain JF-1 / DSM 864)
| 產品貨號 | 產品名稱 | 來源 |
|---|---|---|
| CSB-YP646030MAAQ CSB-EP646030MAAQ CSB-BP646030MAAQ CSB-MP646030MAAQ CSB-EP646030MAAQ-B |
Recombinant Methanospirillum hungatei Enolase 1 (eno1) | Yeast E.coli Baculovirus Mammalian cell In Vivo Biotinylation in E.coli |
ENO1 Proteins for Oryza sativa subsp. japonica (Rice)
| 產品貨號 | 產品名稱 | 來源 |
|---|---|---|
| CSB-YP672606OFG CSB-EP672606OFG CSB-BP672606OFG CSB-MP672606OFG CSB-EP672606OFG-B |
Recombinant Oryza sativa subsp. japonica Enolase (ENO1) | Yeast E.coli Baculovirus Mammalian cell In Vivo Biotinylation in E.coli |
ENO1 Proteins for Pseudomonas syringae pv. syringae (strain B728a)
| 產品貨號 | 產品名稱 | 來源 |
|---|---|---|
| CSB-YP700480PWE CSB-EP700480PWE CSB-BP700480PWE CSB-MP700480PWE CSB-EP700480PWE-B |
Recombinant Pseudomonas syringae pv. syringae Enolase 1 (eno1) | Yeast E.coli Baculovirus Mammalian cell In Vivo Biotinylation in E.coli |
ENO1 Proteins for Macaca fascicularis (Crab-eating macaque) (Cynomolgus monkey)
| 產品貨號 | 產品名稱 | 來源 |
|---|---|---|
| CSB-YP706135MOV CSB-EP706135MOV CSB-BP706135MOV CSB-MP706135MOV CSB-EP706135MOV-B |
Recombinant Macaca fascicularis Alpha-enolase (ENO1) | Yeast E.coli Baculovirus Mammalian cell In Vivo Biotinylation in E.coli |
ENO1 Proteins for Pongo abelii (Sumatran orangutan)
| 產品貨號 | 產品名稱 | 來源 |
|---|---|---|
| CSB-YP722307PYX CSB-EP722307PYX CSB-BP722307PYX CSB-MP722307PYX CSB-EP722307PYX-B |
Recombinant Pongo abelii Alpha-enolase (ENO1) | Yeast E.coli Baculovirus Mammalian cell In Vivo Biotinylation in E.coli |
ENO1 Proteins for Methylococcus capsulatus (strain ATCC 33009 / NCIMB 11132 / Bath)
| 產品貨號 | 產品名稱 | 來源 |
|---|---|---|
| CSB-YP730652MFM CSB-EP730652MFM CSB-BP730652MFM CSB-MP730652MFM CSB-EP730652MFM-B |
Recombinant Methylococcus capsulatus Enolase 1 (eno1) | Yeast E.coli Baculovirus Mammalian cell In Vivo Biotinylation in E.coli |
ENO1 Proteins for Debaryomyces hansenii (strain ATCC 36239 / CBS 767 / JCM 1990 / NBRC 0083 / IGC 2968) (Yeast) (Torulaspora hansenii)
| 產品貨號 | 產品名稱 | 來源 |
|---|---|---|
| CSB-YP731917DIS CSB-EP731917DIS CSB-BP731917DIS CSB-MP731917DIS CSB-EP731917DIS-B |
Recombinant Debaryomyces hansenii Enolase 1 (ENO1) | Yeast E.coli Baculovirus Mammalian cell In Vivo Biotinylation in E.coli |
ENO1 Proteins for Lactobacillus johnsonii (strain CNCM I-12250 / La1 / NCC 533)
| 產品貨號 | 產品名稱 | 來源 |
|---|---|---|
| CSB-YP758657LAW CSB-EP758657LAW CSB-BP758657LAW CSB-MP758657LAW CSB-EP758657LAW-B |
Recombinant Lactobacillus johnsonii Enolase 1 (eno1) | Yeast E.coli Baculovirus Mammalian cell In Vivo Biotinylation in E.coli |
ENO1 Proteins for Candida glabrata (strain ATCC 2001 / CBS 138 / JCM 3761 / NBRC 0622 / NRRL Y-65) (Yeast) (Torulopsis glabrata)
| 產品貨號 | 產品名稱 | 來源 |
|---|---|---|
| CSB-YP763769CZI CSB-EP763769CZI CSB-BP763769CZI CSB-MP763769CZI CSB-EP763769CZI-B |
Recombinant Candida glabrata Enolase 1 (ENO1) | Yeast E.coli Baculovirus Mammalian cell In Vivo Biotinylation in E.coli |
ENO1 Proteins for Cryphonectria parasitica (Chesnut blight fungus) (Endothia parasitica)
| 產品貨號 | 產品名稱 | 來源 |
|---|---|---|
| CSB-YP764866DYH CSB-EP764866DYH CSB-BP764866DYH CSB-MP764866DYH CSB-EP764866DYH-B |
Recombinant Cryphonectria parasitica Enolase (ENO1) | Yeast E.coli Baculovirus Mammalian cell In Vivo Biotinylation in E.coli |
ENO1 Proteins for Pseudomonas syringae pv. tomato (strain DC3000)
| 產品貨號 | 產品名稱 | 來源 |
|---|---|---|
| CSB-YP803408FGP CSB-EP803408FGP CSB-BP803408FGP CSB-MP803408FGP CSB-EP803408FGP-B |
Recombinant Pseudomonas syringae pv. tomato Enolase 1 (eno1) | Yeast E.coli Baculovirus Mammalian cell In Vivo Biotinylation in E.coli |
ENO1 Proteins for Lactobacillus plantarum (strain ATCC BAA-793 / NCIMB 8826 / WCFS1)
| 產品貨號 | 產品名稱 | 來源 |
|---|---|---|
| CSB-YP806092LMS CSB-EP806092LMS CSB-BP806092LMS CSB-MP806092LMS CSB-EP806092LMS-B |
Recombinant Lactobacillus plantarum Enolase 1 (eno1) | Yeast E.coli Baculovirus Mammalian cell In Vivo Biotinylation in E.coli |
ENO1 Proteins for Chlorobium tepidum (strain ATCC 49652 / DSM 12025 / TLS)
| 產品貨號 | 產品名稱 | 來源 |
|---|---|---|
| CSB-YP817084DST CSB-EP817084DST CSB-BP817084DST CSB-MP817084DST CSB-EP817084DST-B |
Recombinant Chlorobium tepidum Enolase 1 (eno1) | Yeast E.coli Baculovirus Mammalian cell In Vivo Biotinylation in E.coli |
ENO1 Proteins for Streptomyces coelicolor (strain ATCC BAA-471 / A3(2) / M145)
| 產品貨號 | 產品名稱 | 來源 |
|---|---|---|
| CSB-YP866876FOB CSB-EP866876FOB CSB-BP866876FOB CSB-MP866876FOB CSB-EP866876FOB-B |
Recombinant Streptomyces coelicolor Enolase 1 (eno1) | Yeast E.coli Baculovirus Mammalian cell In Vivo Biotinylation in E.coli |
ENO1 Proteins for Arabidopsis thaliana (Mouse-ear cress)
| 產品貨號 | 產品名稱 | 來源 |
|---|---|---|
| CSB-YP874925DOA CSB-EP874925DOA CSB-BP874925DOA CSB-MP874925DOA CSB-EP874925DOA-B |
Recombinant Arabidopsis thaliana Enolase 1, chloroplastic (ENO1) | Yeast E.coli Baculovirus Mammalian cell In Vivo Biotinylation in E.coli |
ENO1 Proteins for Lactococcus lactis subsp. lactis (strain IL1403) (Streptococcus lactis)
| 產品貨號 | 產品名稱 | 來源 |
|---|---|---|
| CSB-YP883798LNG CSB-EP883798LNG CSB-BP883798LNG CSB-MP883798LNG CSB-EP883798LNG-B |
Recombinant Lactococcus lactis subsp. lactis Enolase 1 (eno1) | Yeast E.coli Baculovirus Mammalian cell In Vivo Biotinylation in E.coli |
ENO1 Proteins for Hevea brasiliensis (Para rubber tree) (Siphonia brasiliensis)
| 產品貨號 | 產品名稱 | 來源 |
|---|---|---|
| CSB-YP885326HWI CSB-EP885326HWI CSB-BP885326HWI CSB-MP885326HWI CSB-EP885326HWI-B |
Recombinant Hevea brasiliensis Enolase 1 (ENO1) | Yeast E.coli Baculovirus Mammalian cell In Vivo Biotinylation in E.coli |
ENO1 Proteins for Toxoplasma gondii
| 產品貨號 | 產品名稱 | 來源 |
|---|---|---|
| CSB-YP886998TOV CSB-EP886998TOV CSB-BP886998TOV CSB-MP886998TOV CSB-EP886998TOV-B |
Recombinant Enolase 1 (ENO1) | Yeast E.coli Baculovirus Mammalian cell In Vivo Biotinylation in E.coli |
ENO1 Proteins for Bos taurus (Bovine)
| 產品貨號 | 產品名稱 | 來源 |
|---|---|---|
| CSB-YP895935BO CSB-EP895935BO CSB-BP895935BO CSB-MP895935BO CSB-EP895935BO-B |
Recombinant Bovine Alpha-enolase (ENO1) | Yeast E.coli Baculovirus Mammalian cell In Vivo Biotinylation in E.coli |
ENO1 ELISA Kit
ENO1 ELISA Kit for Homo sapiens (Human)
| 產品貨號 | 產品名稱 | 樣本類型 | 靈敏度 |
|---|---|---|---|
| CSB-E17177h | Human Alpha-enolase (ENO1/ENO1L1/MBPB1/MPB1) ELISA kit | serum, tissue homogenates, plasma | 0.078 ng/mL |
ENO1 ELISA Kit for Mus musculus (Mouse)
| 產品貨號 | 產品名稱 | 樣本類型 | 靈敏度 |
|---|---|---|---|
| CSB-EL007670MO | Mouse Alpha-enolase(ENO1) ELISA kit | serum, plasma, tissue homogenates | 15.6 pg/mL |
ENO1 ELISA Kit for Rattus norvegicus (Rat)
| 產品貨號 | 產品名稱 | 樣本類型 | 靈敏度 |
|---|---|---|---|
| CSB-E17439r | Rat α-enolase ELISA Kit | serum, plasma, tissue homogenates | 0.156 ng/mL |












